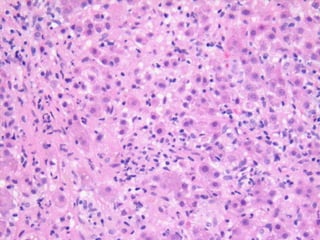
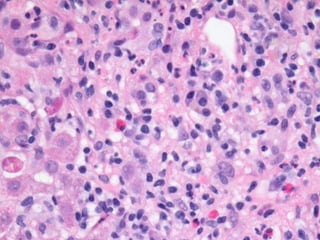
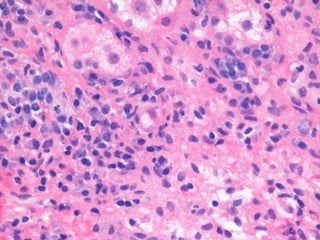
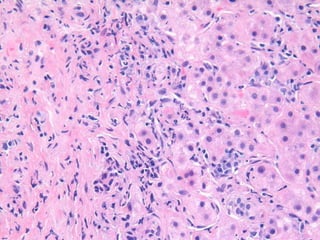
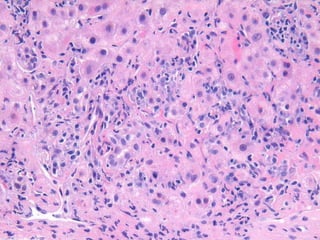

This document contains summaries of liver biopsy results from multiple patients. It describes cases of autoimmune hepatitis, primary biliary cirrhosis, primary sclerosing cholangitis, and overlapping autoimmune syndromes. The biopsies showed features ranging from mild disease to cirrhosis. Diagnoses included autoimmune hepatitis, primary biliary cirrhosis, primary sclerosing cholangitis, and possible overlapping conditions.